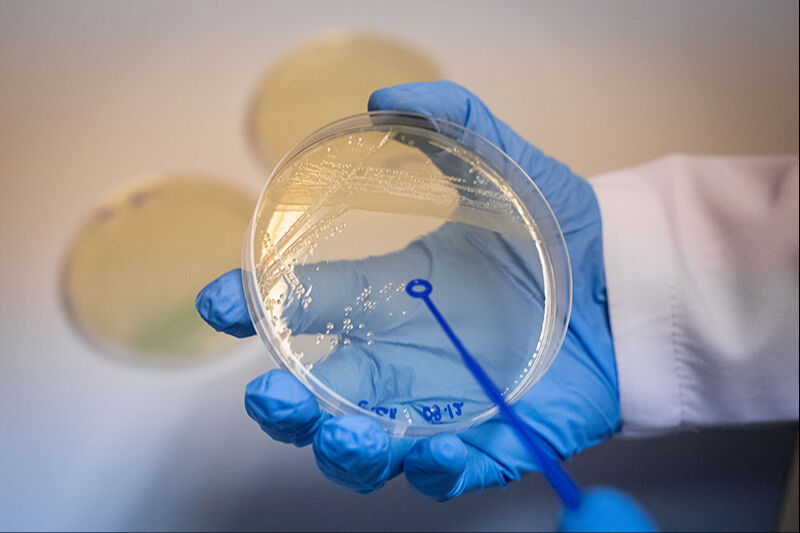
Müsilaja virüslü çözüm! Zararlı mikroorganizmaları azaltan yöntem bulundu - 2. Resim

Müsilaja virüslü çözüm! Zararlı mikroorganizmaları azaltan yöntem bulundu
Denizleri istila eden müsilaj tehlikesi gittikçe korkunç bir hal alırken Ankara Üniversitesi'nde sevindiren bir çözüm üretildi. Öğretim Üyesi Doç. Dr. Banu Kaşkatepe, müsilaj yapı içerisinde hastalık yapan mikroorganizmaların miktarını, bakteri yiyen virüsleri kullanarak azaltmayı başardıklarını söyleyerek mücadele stratejisini anlattı.
Ankara Üniversitesi Eczacılık Fakültesi Temel Eczacılık Bilimleri Bölümü Öğretim Üyesi Doç. Dr. Banu Kaşkatepe, Marmara Denizi'nde 2021'den beri görülen müsilaj oluşumu için çözüm üretildiğini bildirdi.
Müsilaj deniz ekosistemini tehdit edecek boyutlara ulaşmış, TÜBİTAK, müsilajın olumsuz etkilerini önlemeye yönelik projelere destek açıklayan bir çağrıda bulunmuştu.
Ankara Üniversitesi ve İstanbul Üniversitesi-Cerrahpaşa işbirliğinde yürütülen "Marmara Denizi Enterik Patojenlerine Özgü Litik Bakteriofajlar İle Etkin Biyosürfaktan Ramnolipidin Birlikte Kullanımının Müsilaj Üzerine Olası Etkinliğinin Belirlenmesi" başlıklı çalışma da bu çağrıya çözüm üreten projelerden biri oldu.

MÜSİLAJIN VERDİĞİ KORKUNÇ ZARARLAR
Araştırmanın yürütücüsü Kaşkatepe, halk dilinde deniz salyası olarak bilinen müsilajı, biyolojik ve kimyasal birçok etmenin bir araya gelerek oluşturduğu, bitkisel deniz canlılarının sayısının, deniz suyu sıcaklığının ve bakteriyel birtakım aktivitelerin artmasına bağlı olarak meydana gelen sümüksü bir yapı olarak tanımladı.
Müsilajın denizel ortamdaki biyoçeşitliliği tamamen değiştirdiğini belirten Kaşkatepe şunları söyledi:
"Müsilaj tamamen yüzeyi kaplıyor ve güneş ışınlarının girmesini engelliyor. Bir taraftan yoğun bir yapı olduğu için balıkların solungaçlarını tıkayabiliyor. Balıkların oksijensiz kalmasına ve ölmesine neden oluyor. Oradaki çeşitliliği değiştiriyor ama bir yandan da bunun turizme, denizciliğe etkisi var. Müsilaj yapı içerisinde aslında özellikle zararlı, bize hastalık oluşturacak bakterilerin yoğun olarak arttığını da biliyoruz. Bu bakteriler, müsilaj yapı içerisinde binlerce kat daha fazla artıyorlar, dolayısıyla bu anlamda da bir halk sağlığı sorunu haline geliyorlar."
Marmara Denizi'nde artan bu tür enterik patojen bakteri sayısını yine doğal çözümlerle azaltmaya çalıştıklarını söyleyen Kaşkatepe, denizin kendi yapısında var olan bakteriyofajları (bakteri yiyen virüsleri) izole ederek çoğalttıklarını ve yüzey aktif bir madde olan biyosürfaktanla birlikte bakterileri bertaraf etmek için etkinliklerini değerlendirdiklerini kaydetti.
BAKTERİLERİN YÜZDE 99,99 ORANINDA AZALDI
Proje kapsamında Marmara Denizi'ndeki 9 farklı istasyondan su örneği aldıklarını ve 5 ay boyunca bu su örneklerinin müsilaj öncesi ve sonrası parametrelerini karşılaştırdıklarını aktaran Kaşkatepe, şöyle devam etti:
"Önce bu su örneklerinden etken olan, hastalık yapıcı bakterileri elde ettik. Sonra aynı örneklerden bakteri yiyen virüsleri elde ettik. Bu virüslerin bu bakteriler üzerine etkinliğini değerlendirdik ki en etkin olan bakteri yiyen virüsü kullanabilelim ve bunlardan bir karışım oluşturabilelim diye. Deniz suyunu kontamine ederek uyguladığımız ve faj kokteyli adını verdiğimiz bu karışımla, sayının ne kadar azaldığını inceledik ve çok yüksek etkinlik elde ettik. Laboratuvar koşullarında, deniz suyunda uyguladığımız prosesle, bakterilerin yüzde 99,99 oranında azalabildiğini gözlemledik."
Kaşkatepe, araştırma sonucunda elde ettikleri bilgiler doğrultusunda mikroorganizmaların miktarını azaltmaya yönelik neler yapabileceklerini bildiklerini ve yeni bir müsilaj oluşumunda biyolojik mücadele gerçekleştirebileceklerini dile getirdi.
Biyolojik yöntemlerle geliştirilen bu bakterilerin denize verilmesi durumunda ekosisteme bir zararının olmayacağını ifade eden Kaşkatepe, "Biz zaten Marmara Denizi'nin kendi doğasında var olanı kendi yararına kullanıyoruz. Bu fajları da yine Marmara Denizi'nin kendisinden izole ediyoruz. Sadece daha etkinlik düzeyi yüksek olacak derecede uyguluyoruz ve bunlar etken spesifik oldukları için aslında sadece kendilerine özgü bakterileri bertaraf edecekler. Dolayısıyla o ekosistemdeki diğer bakterilerin üzerinde etkili olmaları beklenmediği için bu anlamda da bir zararının olmayacağı düşünülüyor." diye konuştu.
TÜRKİYE'DE BİR İLK
Özellikle denizdeki atıkların müsilaj yayılımını hızlandırdığına dikkati çeken Kaşkatepe, müsilajla kimyasal yollarla mücadele edilmesinin durumu daha da kötüleştirebileceğini, bu yüzden doğal çözümlerin önemli olduğuna işaret etti.
Araştırmanın Türkiye'de deniz ortamında bakteri yiyen virüsler konusunda bir ilk olduğunu vurgulayan Kaşkatepe, literatürde müsilajda biyosürfaktan madde ve bakteriyofajın birlikte etkinliğini araştıran başka bir çalışma olmadığına ve araştırma sonuçlarının, etkinliği yüksek bir dergide yayımlandığına değindi.
Kaşkatepe, iklim değişikliğine bağlı artan deniz suyu sıcaklıkları nedeniyle müsilajla ilgili yapılan araştırma ve çalışmaların öneminin gün geçtikçe daha iyi anlaşılacağı değerlendirmesinde bulundu.





















